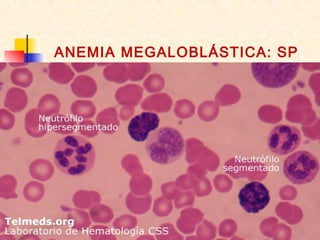
ANEMIA MEGALOBLÁSTICA: SP
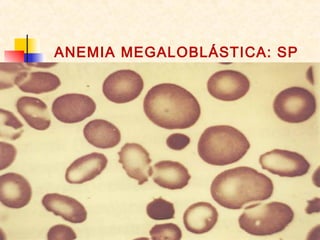
ANEMIA MEGALOBLÁSTICA: SP

A anemia ferropriva é um problema significativo de saúde pública, especialmente entre mulheres e crianças em países em desenvolvimento, com alta prevalência no Brasil. Fatores como baixa ingestão de ferro e perda de sangue contribuem para sua ocorrência, e o tratamento envolve reposição de ferro, orientação nutricional e identificação das causas subjacentes. A prevenção e o tratamento eficaz são essenciais para reduzir os impactos da anemia nas populações afetadas.






















![TRATAMENTO
Cálculo da dose (mg total) e via de
administração do ferro sacarato
Tratamento da anemia ferropriva com ferro por via parenteral.
Cançado RD et al. Rev. Bras. Hematol. Hemoter. 2010;32(Supl. 2):121-128
[Hb (g/dL) desejada – Hb atual] x peso corporal (Kg) x 2,4 + 500
• Embora a administração de ferro por via IM tenha sido muito usada, sobretudo
em função da experiência negativa com o ferro dextran por via EV na década de
80 e pela facilidade de aplicação, esta via de administração tem sido
gradativamente substituída pela via IV
• Recomenda-se a dose IM máxima diária de 200mg (duas ampolas) de sacarato
• Na prática, orienta-se a aplicação de uma ampola, uma a duas vezes por semana,
até que se complete a dose total desejada ou calculada
• Sabe-se que o ferro aplicado por via IM tem absorção irregular e efeitos adversos
indesejáveis, como dor, mancha hipercrômica e necrose muscular (rara) no local
da aplicação. A ocorrência desses EA pode ser menos frequente quando a
técnica de aplicação escolhida é a intramuscular em Z](https://image.slidesharecdn.com/3-anemiascarenciais-130813101514-phpapp01/85/3-Anemias-Carenciais-23-320.jpg)